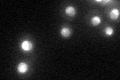
YPR169W
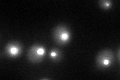
YPR169W
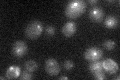
YPR169W

View description
Essential protein of unknown function; interacts with proteins involved in RNA processing, ribosome biogenesis, ubiquitination and demethylation; tagged protein localizes to nucleus and nucleolus; similar to WDR55, a human WD repeat protein
Localization:
Intensity:
Fold change:
Significance:
-
C’ GFP library in SD
nucleus49.43 -
N' NOP1pr-GFP in SD

nucleus,nucleolus97.1352 -
N' TEF2pr-mCherry in SD

nucleus,nucleolus91.179 -
N' NATIVEpr-GFP in SD

nucleus,nucleolus39.0498 -
N' TEF2pr-VC and Cyto-VN in SD

nucleus,nucleolus57.4567 -
C’ GFP library in SD+DTT
nucleus38.080.77No -
C’ GFP library in SD+H2O2

punctate, nucleusN/AN/ANo -
C’ GFP library in Starvation Media
punctateN/AN/AYes -
C’ GFP library on the background of Pup2-DaMP

nucleus -
C’ GFP library on the background of CCT mutant

nucleus47.21180.954948No
